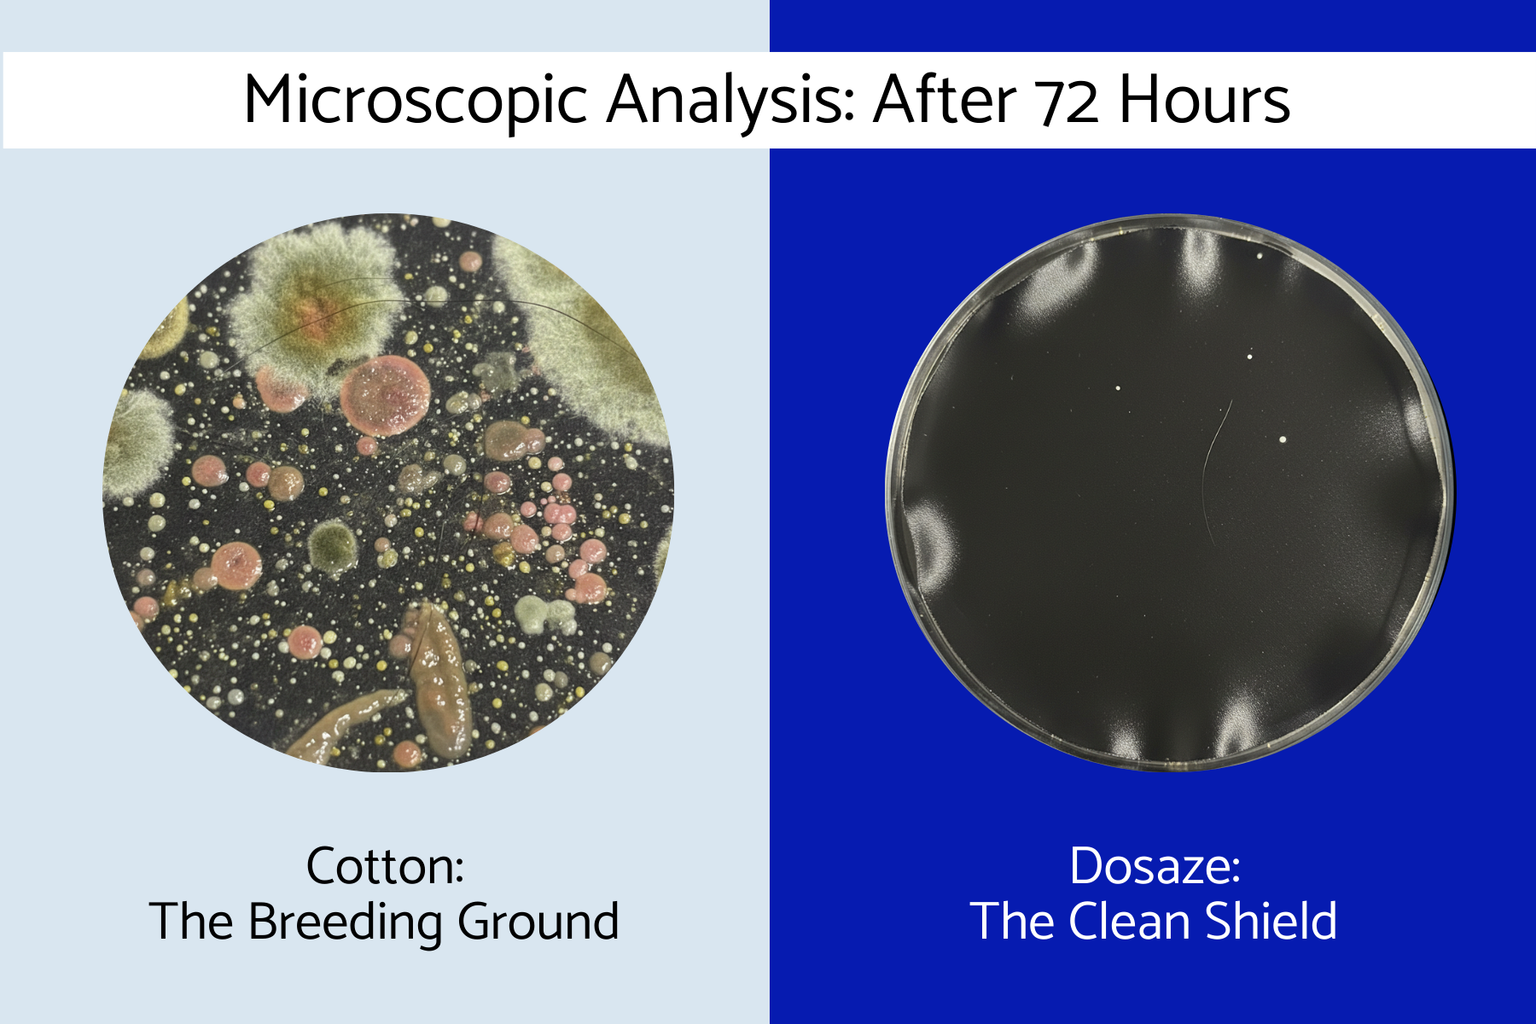

At Dosaze, we believe what touches your hair and skin for 6–8 hours every night should be made with intention. That’s why we use only 100% 6A Grade Mulberry silk at a dense 22 momme weight, infused with silver antimicrobial technology and certified to OEKO-TEX® standards.
We carefully selected our manufacturing partners, tested every detail, and refused to cut corners on materials. No synthetic blends. No inflated markups. Just high-performance silk designed to support better sleep, smoother hair, and clearer-looking skin.
We stand behind our quality which is why every pillowcase comes with a 60-night risk-free trial.
Because better mornings start the night before.
Returns Policy
We offer a 60-night risk-free trial on all Dosaze™ Silk Pillowcases.
If you’re not completely satisfied within 60 nights of delivery, you may return your pillowcase for a full refund.
To start a return, email support@dosaze.com with your order number, and our team will guide you through the process.
Simple. Stress-free. Designed with your peace of mind in mind.
For the tired, back pain ridden, masses.
Welcome Home.
Back pain doesn’t just come and go. It’s always there.
And you know how debilitating it is.
Back pain can severely impact your quality of sleep, and your quality of life.
Some mattresses promise a solution. Sadly, most mattresses just can’t back it up with features that will actually make a difference.
There’s nothing wrong with these mattresses, they just don’t go the extra mile to actually relieve your back pain — and you know why they don’t really work? Because they don’t target the actual root causes of back pain when you sleep — pressure points, misalignment, and improper support / firmness.
Most mattresses use one layer (or use multiple, thin layers) of foam to relieve pressure points — or, they cheat and use cheaper foam.
In their support layers, they don’t provide enough support for your midsection, so you’ll have a tendency to sink into your mattress.
And finally, they’re usually too firm — did you know that medium firm is the best firmness for back pain relief, according to research? Contrary to popular belief, you don’t need an extra firm mattress to relieve back pain.
Here’s what happens when you send a regular mattress to do the job of a DreamAlign Hybrid Back Relief Mattress=

For a number of reasons, these mattresses simply can’t compete with how much support and relief the DreamAlign mattress can give you.
First, they do not provide adequate support— these mattresses are often made with cheap quality foam or coils that tend to sink when you lie on them. You know, like those cheap innerspring mattresses that you’ve slept on when traveling. You can see how this would cause poor alignment.
Second, most mattresses aren’t actually designed to relieve back pain. You need more than just a “nice” mattress, you need one where every feature was designed to relieve back pain.
Without having all of these elements together, you simply get a mattress that might be nice, but that doesn’t actually relieve back pain and improve your sleep quality.
Enough Already!
Starting from scratch has its advantages. And the need for a three pronged approach to relieving pain was clear to us early.
It’s not just about hype or promises, either.
If it was, we would have used not certified foam, traditional springs, or made our mattress in lower cost markets.
We wanted something not too hard (it would hurt your back), not too soft (it wouldn’t support your body), and definitely not something too hot. It needed to be just right.
We tested ~50 different foam blends and firmness levels with people from all walks of life. Some started off promising, and in the end, all failed. It was so hard we nearly abandoned the project. In the end, we did something experts told us we would never be able to do: we created our own proprietary mattress.
This mattress couldn’t have existed 5 years ago
There is a reason you didn’t see us when you shopped for your last pillow. The technology behind the Dosaze DreamAlign mattress didn’t exist.
We crafted this mattress to solve the support and alignment issues plaguing us and our loved ones — we saw the issues with current pillows and solved them meticulously one by one.
If you’ve made it this far, we want to say thank you. Thank you for allowing us to share our journey to create the perfect mattress with you.There’s a lot of pressure to buy now, act now. Don’t feel rushed. We aren’t going anywhere. And when you’re ready, we look forward to giving you the best quality sleep of your lift. If you have any questions, you can reach our founder, Inno, directly @ inno@dosaze.com and we can answer any questions you have!
And if you try it, and our pillow doesn’t help you, no harm, no foul. You can try our mattress for 365 nights and get a full refund, no questions asked, if you don’t like it.
We look forward to you joining the millions that are sleeping better with Dosaze.
Custom code block
Use this advanced section to add custom HTML, app scripts, or liquid.
Custom code block
Use this advanced section to add custom HTML, app scripts, or liquid.
100% Mulberry Silk Pillowcase
Summer Sale!
Buy One, Get One Free ($130 Value)
Summer Sale!
Buy One, Get One Free ($130 Value)
100% Mulberry Silk Pillowcase



Your Overnight Beauty Essential. Made with 22 Momme Mulberry Silk and Silver-Infused Protection.

Dosaze ThermaCool™ Sheet Set Upgrade
- White / Twin / 1 Sheet Set — Sold out
- White / Twin XL / 1 Sheet Set
- White / Full / 1 Sheet Set
- White / Queen / 1 Sheet Set
- White / King / 1 Sheet Set
- White / Cal King / 1 Sheet Set
- Slate / Twin / 1 Sheet Set
- Slate / Twin XL / 1 Sheet Set
- Slate / Full / 1 Sheet Set
- Slate / Queen / 1 Sheet Set
- Slate / King / 1 Sheet Set
- Slate / Cal King / 1 Sheet Set
- Cream / Twin / 1 Sheet Set
- Cream / Twin XL / 1 Sheet Set
- Cream / Full / 1 Sheet Set
- Cream / Queen / 1 Sheet Set
- Cream / King / 1 Sheet Set
- Cream / Cal King / 1 Sheet Set

Dosaze Contoured Orthopedic Pillow Upgrade
- Standard / 1-Pack
- Standard / Comfort Bundle (1 Pillow + 1 Pillow Protector) (Save $5)
- Standard / 2-Pack (Save $20)
- Standard / Double Comfort Bundle (2 Pillows + 2 Pillow Protectors) (Save $50)
- Thick / 1-Pack
- Thick / Comfort Bundle (1 Pillow + 1 Pillow Protector) (Save $5)
- Thick / 2-Pack (Save $20)
- Thick / Double Comfort Bundle (2 Pillows + 2 Pillow Protectors) (Save $50)